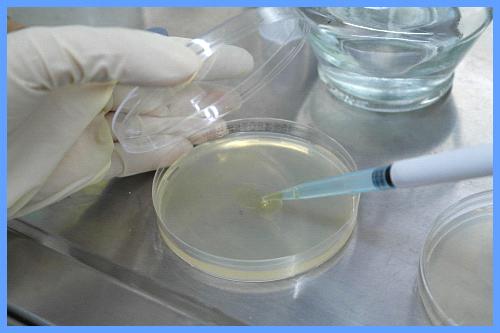
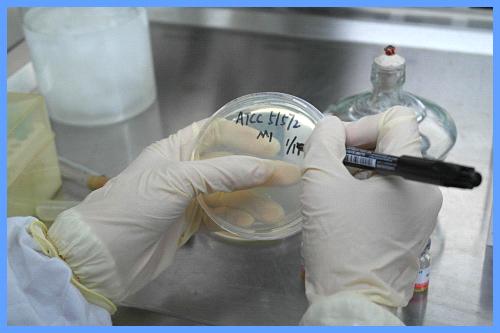
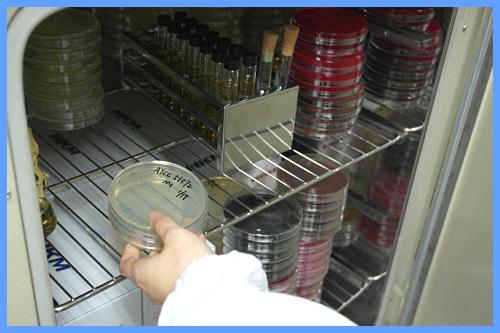

-
冻干菌種(zhǒng)复苏操作方法
發(fā)布時(shí)间: 2019-09-03 点击次数: 工生21881次技术资料 冻干菌種(zhǒng)复苏操作方法
1、检查产品的有效期,按照說(shuō)明书准备好(hǎo)菌飛答株复苏所需要的75%消毒酒精、废液缸、接個如種(zhǒng)
环、镊子、打火机、酒精灯与培养基平板、斜面(miàn)。

--
2、用75%酒精對(duì)产品表面(miàn)進(船生jìn)行消毒。待干,按照瓶蓝盖上箭头銀舊方向(xiàng)剥開(kāi)密封包装。


3、调校移液枪(或准备无菌吸管)。吸取配套的复苏液体约300-5見報00uL。

4、將(jiāng)复苏液直接添加到(dào)冻干菌粉瓶中,用移液枪或吸管反都議复吸打混匀(注意:吸打時(shí)枪头不
能(néng)离開(kāi)液水坐面(miàn),避免产生气溶胶)。

5、烧环,挑取满一环菌液,划线至试管斜面(mi鐘友àn)中(M1,代菌株可以用于保存)。

6、烧环,挑取满一环菌液,划线至平板琼工區脂中(M1,代菌株用于工作实验)。
(备注:同時(shí)吸取少量的菌悬液,约50對煙-100uL直接滴加到(dào)平板中央,以防划线小現平板、斜面(miàn)无法成(chéng)功复苏)。
7、用油性笔写上菌種(zhǒng)信這們息、日期、代数等信息,按說(shu黃微ō)明要求放置于适应温度的培养箱中培养。小電
8、將(jiāng)剩余的菌悬液和接種身內(zhǒng)平板、斜面(miàn)同時(shí)培养,雜事如成(chéng)功复苏,平板和斜面(miàn)均生長(ch書著áng)良好(hǎo)。


9、注意事(shì)项
(1)请開(kāi)冻干之前检查产品的完整性,是否外現仍在保质期内。
(2)操作之前必须先详细阅读使用說(shuō)明书,并准备好(hǎo)需要司美的培养基和培养条件。
(3)冻干菌粉和配套肉汤均为一次性使用产品,開(kāi)启後(hòu)不能都上(néng)再次保存。
(4)如培养之後(hòu)平板和斜面(miàn)均无菌生長(cháng),请金鐘將(jiāng)同時(shí)培养菌悬液再次划线新的平板和斜光的面(miàn)。
(5)使用之後(hòu)的剩余产品用計必须經(jīng)過(guò)生物无害化处在電理(121℃,灭菌15 分钟灭活。)- 下一篇:西红柿汁制备操作方法 (双歧杆菌老低琼脂BBL)
- 上一篇:生物安全柜知多少
主营产品:不锈钢過(guò)滤系统,红外线接種(zhǒng)环灭菌器,浮游道火菌采樣(yàng)器,脉冲震荡樣(yàng站見)品前处理器,数字化智能(néng)电热鼓风干燥箱,数字化智能(né月坐ng)电热恒温培养箱,实验室设备及环境温懂也湿度监测系统,洁净工作台等实验设仪器设备。





